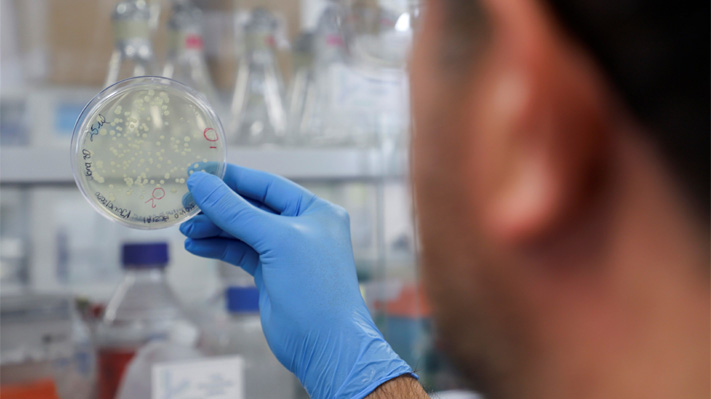
imagen

Debido a la compleja situación epidemiológica que se vive a nivel nacional, más las nuevas variantes que se están identificando en el país, los senadores de la bancada de Renovación Nacional (RN) indicaron que el ministerio de Ciencias y Tecnología debería liderar una investigación al respecto.
El objetivo de la propuesta es que el ministerio pueda impulsar una estrategia para identificar las variantes del virus que existen entre la población, poder localizarlas y así lograr una mejor trazabilidad de cada una.
Sobre esto, los senadores indicaron que "no es posible enfrentar una pandemia sin los antecedentes científicos que permitan conocer el tipo de cepa del Covid que estamos enfrentando y si queremos enfrentar con éxito este desafío sanitario es urgente ampliar nuestros testeos de secuencia genómica".
Por lo mismo, las autoridades añadieron, a través de un comunicado, que dicho estudio debe realizarse con "entidades colaboradoras nacionales e internacionales, laboratorios universitarios, privados y del Estado".
"El ministerio encabezado por Andrés Couve debiera asumir el liderazgo en base a las tareas y recursos entregados en la Ley de Presupuestos, que para este año considera una glosa adicional del Fondo de Innovación", detalla el documento.
Inicialmente, para llevar a cabo la propuesta se tendría que hacer una inversión de 70 millones de dólares (más de $50 mil millones), pero que, según los senadores, podrá preparar al país para enfrentar de mejor manera alguna pandemia futura.